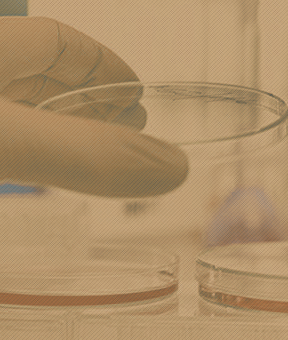

請雙擊輸入文字


聯(lián)系我們
鎮(zhèn)江利晟節(jié)能環(huán)??萍加邢薰臼翘樟?、陶粒砌塊、陶粒免燒磚、陶粒等產(chǎn)品專業(yè)生產(chǎn)加工的企業(yè),主營建筑陶粒、回填陶粒、花卉陶粒、陶粒沙,規(guī)格齊全。歡迎廣大客戶光臨鎮(zhèn)江利晟節(jié)能環(huán)保科技有限公司,訂購銷售熱線:18020495288


Copyright © 2021-2026,www.lsjn18351875388.cn,鎮(zhèn)江利晟節(jié)能環(huán)??萍加邢薰? All rights reserved 粵ICP備2020110074號